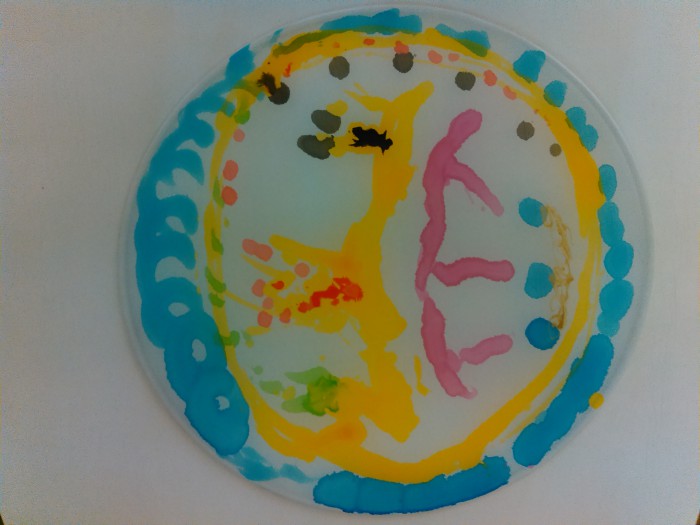

Peregrinus. Renesanční poutník
úterý 3. března 2020
Ve víru světa - ve víru světla
Představte si barvitý renesanční svět a v něm člověka, který si začíná mnohem lépe a intenzivněji než dosud uvědomovat svoje místo v něm: geografické souvislosti i vlastní vztah k tomu, co nás přesahuje. Lidská touha poznávat – sám sebe i rychle sílící ruch života kolem – se nutně odrazila také v poutnictví, jak ho dnes známe z vrcholných děl tehdejší literatury.
Během pořadu jsme prošli 300 let evropské kultury postupně s pěti poutníky: Dantem a jeho Božskou komedií od temného lesa, pekla až rezonujícímu bílému tichu ráje, s Chaucerem a jeho třiceti poutníky do Cantebury a zpět do hospody, s Villonem a jeho protloukáním se drsným světem pozdně středověkého velkoměsta - Paříže 15. století, s Pantagruelem fantaskním světěm renesančního humoru v nadsázce až k branám samotného Ideálního místa pro život (Thelémského opatství) a nakonec s Donem Quijotem až k bolestnému poznání, že můj ideál nemusí být slučitelný s okolním světem, a velkým smířením se s tímto poznáním; díky němu jsme mohli podobně jako on po této velkolepé pouti skončit "s klidnou myslí na prahu rodné vsi".
V průběhu tohoto putování za živým odkazem renesančního myšlení jsme postupně do symbolu kruhu (mandaly, chcete-li), který nám v návaznosti na symboliku zmíněných renesančních děl dočasně značil náš osobní vesmír - naši duši a její svět, přenášeli, vyjadřovali naše bezeslovné odpovědi na tyto otázky a podněty:
Co vám zostří, zjitří smysly, abyste se mohli soustředit na své nitro, na božskou jiskru v nás? Meditace? Určitý stupeň únavy? Samota? Dokážete to zaznamenat do svých kruhů?
Zkuste vybrat jeden obyčejný příběh ze svého každodenního života, který váš duchovní svět propojí s všední realitou – drobnost, konkrétní věc, která dodá světu vaší duše osobitost, něžnost, intimitu… Váš "podpis". Vložte něco takového do symbolu světa své duše.
Co byste chtěli odkázat světu kolem vás a proč? – Co byste darovali?
Pokuste se v kruhu vaší duše navodit naprosto svobodné průzračné prostředí, o něž se nebojíte (proto nemá hradby). Založte zde svou Thelému (barvou, linkou, symbolem…)
Každý si prožil, prošel nejrůznějšími hlubinami smutku, neštěstí, tragédií - kolikrát náš ideál a náš vnitřní svět zažil destruktivní střet se světem okolo nás. Cenné je, když dokážeme po takovém otřesu najít klid, spočinutí, smíření. Završte kruh své duše motivem spočinutí, smíření.
Jak to dopadlo, můžete vidět ve fotogalerii...

© 2009 - 2016 Obec širšího společenství